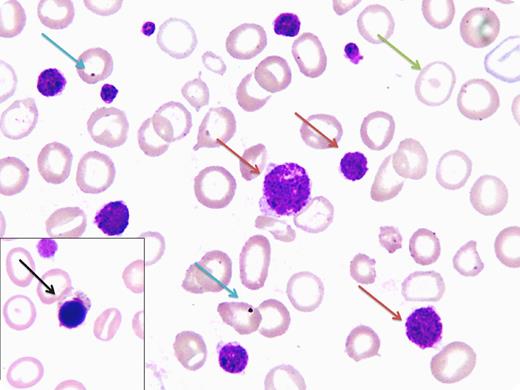

A 23-year-old primigravida woman presented with recurrent mucocutaneous bleeding since the age of 7 years. She was diagnosed with acute immune-mediated thrombocytopenia (ITP), and splenectomy was performed in 2006 after failure to respond to steroid therapy. Two close family members also had significant bleeding issues. Apart from pallor and a 20-weeks gravid uterus, there were no other physical findings. Complete blood count levels showed hemoglobin 5.6 g/L, hematocrit 21%, mean corpuscular volume 76.6 fL, mean corpuscular hemoglobin 20.6 pg, white blood cells 6.6 × 109/L, platelets 20 × 109/L, and mean platelet volume 9.1 fL. Peripheral blood film displayed hypochromic microcytes, macrothrombocytosis (red arrow), and postsplenectomy features such as target cells (green arrow), normoblasts (black arrow), and Howell-Jolly bodies (blue arrow). The platelet level estimate was low-normal on manual counting. Further laboratory workup showed a bleeding time of 5 minutes; ristocetin-defective platelet aggregometry with robust responses to collagen, epinephrine, and adenosine diphosphate; von Willebrand factor 157%; and ristocetin cofactor activity 150%. On the basis of family history, macrothrombocytosis, and platelet aggregometry, our presumed diagnosis was Bernard-Soulier Syndrome (BSS).
BSS is a rare autosomal, recessive platelet dysfunction. A peripheral film review is imperative for correct diagnosis because automated analyzers frequently fail to properly count the giant-sized platelets. Making a definitive diagnosis requires demonstration of absent GPIb-IX-V complex (flow cytometry or sodium dodecyl sulfate–polyacrylamide gel electrophoresis). However, a lack of sophisticated facilities restricted us from conducting such a workup.
A 23-year-old primigravida woman presented with recurrent mucocutaneous bleeding since the age of 7 years. She was diagnosed with acute immune-mediated thrombocytopenia (ITP), and splenectomy was performed in 2006 after failure to respond to steroid therapy. Two close family members also had significant bleeding issues. Apart from pallor and a 20-weeks gravid uterus, there were no other physical findings. Complete blood count levels showed hemoglobin 5.6 g/L, hematocrit 21%, mean corpuscular volume 76.6 fL, mean corpuscular hemoglobin 20.6 pg, white blood cells 6.6 × 109/L, platelets 20 × 109/L, and mean platelet volume 9.1 fL. Peripheral blood film displayed hypochromic microcytes, macrothrombocytosis (red arrow), and postsplenectomy features such as target cells (green arrow), normoblasts (black arrow), and Howell-Jolly bodies (blue arrow). The platelet level estimate was low-normal on manual counting. Further laboratory workup showed a bleeding time of 5 minutes; ristocetin-defective platelet aggregometry with robust responses to collagen, epinephrine, and adenosine diphosphate; von Willebrand factor 157%; and ristocetin cofactor activity 150%. On the basis of family history, macrothrombocytosis, and platelet aggregometry, our presumed diagnosis was Bernard-Soulier Syndrome (BSS).
BSS is a rare autosomal, recessive platelet dysfunction. A peripheral film review is imperative for correct diagnosis because automated analyzers frequently fail to properly count the giant-sized platelets. Making a definitive diagnosis requires demonstration of absent GPIb-IX-V complex (flow cytometry or sodium dodecyl sulfate–polyacrylamide gel electrophoresis). However, a lack of sophisticated facilities restricted us from conducting such a workup.
For additional images, visit the ASH IMAGE BANK, a reference and teaching tool that is continually updated with new atlas and case study images. For more information visit http://imagebank.hematology.org.